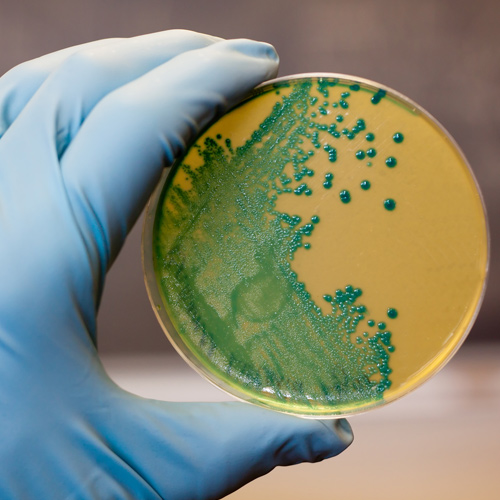
Cómo eliminar la Listeria

APPCC Matadero
Los mataderos deben ser capaces de garantizar que los alimentos cumplan con los requisitos de sanidad y seguridad alimentaria.

Los mataderos son lugares donde a diario se lleva a cabo una manipulación de diferentes tipos de carnes. Entre los problemas más frecuentes se encuentra la contaminación cruzada de los productos que se están tratando, así como que se convierta el propio local en un foco de contaminación.
En cumplimiento con la legislación vigente, establecimientos como los mataderos, comercios minoristas de carnes y en definitiva cualquiera donde se efectúe la manipulación de carnes, deben ser capaces de garantizar que los alimentos cumplan con los requisitos de sanidad y seguridad alimentarias.
El Análisis de Peligros y Puntos de Control Críticos, conocido por sus siglas como APPCC, es un sistema mediante el cual se establece un control sobre los posibles puntos de riesgo existentes. De esta forma se permite a las empresas que lo implementen mantener un control con todo detalle sobre la totalidad de los procesos, garantizando la seguridad alimentaria.
El Sistema APPCC para Mataderos implementado por ASP
El APPCC es un sistema integral que permite establecer un exhaustivo control, evitando presencia de residuos en la recepción de los animales, contaminaciones por el corte o contaminación cruzada de los canales. A la vez, se evitan enfermedades de transmisión a personas y vigilan que las temperaturas utilizadas en las salas de manipulación sean las correctas.
Por ley, son los propios mataderos los que tienen que asegurar la inocuidad de los productos cárnicos que ofrecen. ASP pone a su disposición el sistema APPCC, asegurando que cumplan todos los requisitos legales, así como los sanitarios, evitando fallos durante el proceso y haciendo más eficiente la gestión. La mayor satisfacción de los consumidores, el ahorro económico y la seguridad alimentaria serán alguno de los resultados que se obtendrán contratando el servicio APPCC de ASP.
Descargar el catálogo de sistemas de autocontrol (APPCC)